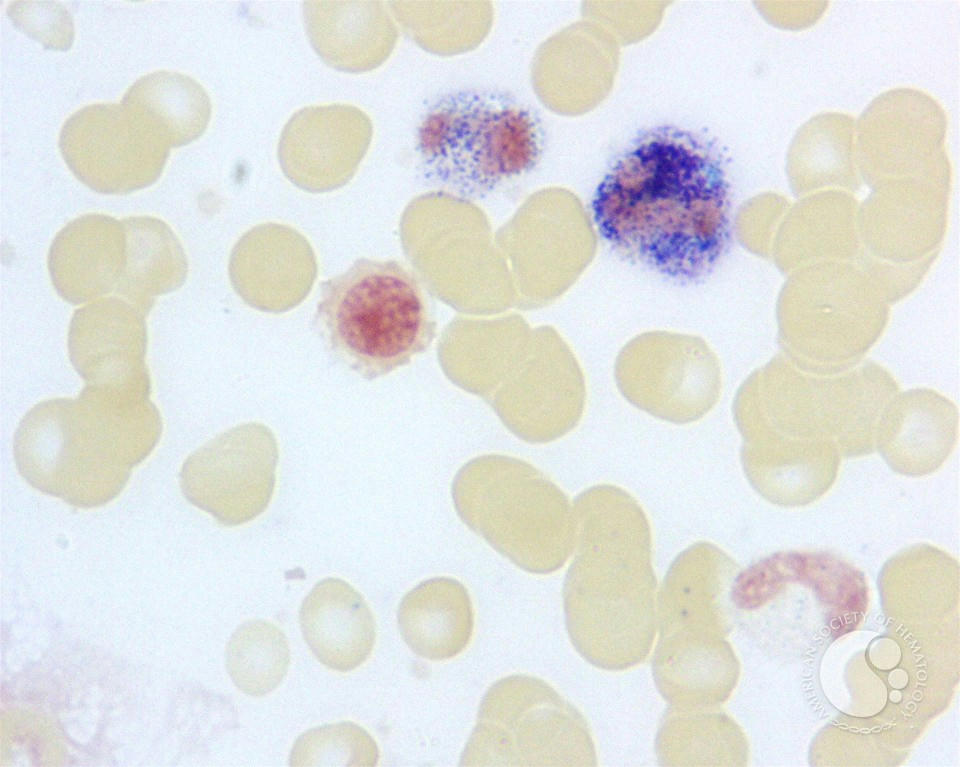

Hoffbrand’s Essential Haematology
Hoffbrand’s Essential Haematology
برای دانلود از لینک تلگرام ما استفاده کنید. حجم فایل 30مگابایت می باشد و به علت حجیم بودن در کانال تلگرامی اپلود شده است. ( دانلود )
بعد از ورود به کانال، وارد قسمت فایلها شده و کتاب هاف براند را دانلود کنید.
برچسبها: هماتولوژی, هاف براند, ویرایش 2016, Hoffbrand’s Essential Haematology
اندازه گیری و تعیین فعالیت Leukocyte alkaline phosphatase (LAP) برای افتراق واکنش لکوموئید(LAP بالا است) از لوسمی میلوئیدی مزمن (CML) استفاده می شود. نمونه مورد استفاده نمونه خون مویرگی یا خون جمع آوری شده با ضد انعقاد هپارین است. گستره تازه تهیه شده و یک ساعت مدت زمان خشک شدن آن می باشد سپس با استون (بافری شده با سیترات) 60% فیکس می شد. گستره های فیکس شده را می توان در فریزر برای یک شب نگه داری کرد. گستره های در نفتول فسفات "AS-MX" و در Ph قلیایی انکوبه می شوند. نفتول آزاد یه سرعت با دیازینوم آزاد جفت می شود و تشکیل پارتیکل های قهوه ای تا سیاه را در سیتوپلاسم سلول های حاوی آنزیم می دهد. بعد از رنگ آمیزی متضاد رنگ آمیزی زمینه ای) گستره خونی با میکروسکوپ بررسی می شود. چون این آنزیم در گرانول های ثانویه گرانلوسیت های بالغ قرار دارد، تعداد 100 عدد از نوتروفیل ها/باند ها شمارش می شوند و برای هر سلول رنجی از میزان آنزیم به صورت صفر تا 4 مثبت را با توجه به شدت رسوب رنگ تعیین می کنیم. تعداد سلول های شمارش شده در هر رنج را ضرب رنج می کنیم و نتیجه آنها را با هم جمع کرده و میزان LAP کلی به دست می آید. نمونه های EDTA نتایج مثبت کاذب را ایجاد می کنند. میزان نرمال LAP بین 130-13 می باشد.

امروزه در جواب برگه آزمایش ها دیف پلات ها به صورت معمول گزارش می شوند. این دیف پلات ها مجموعه ای نقاط هستند که هر نقطه نشان دهنده یک سلول است. محل قرار گیری هر سلول با توجه به اندازه و گرانول های آن متفاوت خواهد بود. برای بررسی دقیق این سلول ها و شناسایی سلول های طبیعی از غیر طبیعی این پلات ها کمک کننده خواهند بود.
شکل زیر مرزهای تقریبی این سلول ها را نشان می دهد. ممکن است در دستگاه های مختلف این مرزها مختلف باشند.
این دو شاخص هماتولوژیک (Red-cell distribution width) معمولا در برگه CBC درج می شوند ولی تفاوت هایی با هم دارند. هر چند بیشتر از RDW-CV استفاده می شود و به صورت درصد گزارش داده می شود ولی این شاخص از نظر هماتولوژیک وابسته به مقدار MCV است و در نتیجه معتبر نمی باشد برای غلبه بر این مشکل از واحد آماری دیگری به عنوان RDW-SD استفاده می شود که واحد آن فمتولیتر است. منظور از عرض در این شاخص (Width) عرض نمودار است نه عرض گلبول های قرمز!
مقادیر نرمال برای RDW-CV، 12.8+-1.2% و برای RDW-SD، 42.5+- 3.5 fl می باشد. حالا سوالی که مطرح می شود این است که چرا RDW-CV تحت تاثیر MCV قرار دارد. برای محاسبه RDW-CV ما از فرمول زیر استفاده می کنیم:

هر عاملی که باعث افزایش کاذب MCV بشود مقادیر RDW-CV را کاهش می دهد. در صورتی که RDW-SD تحت تاثیر قرار نمیگیرد چون یک شاخص آماری واقعی است. شکل زیر کامل تر این تفاوت را نشان می دهد.

امروز در مورد روش خونگیری قدم به قدم با شما خواهیم بود. نمونه خون یکی از مهمترین نمونه های آزمایشگاهی است که توسط آزمایشگاه، پرستار، پزشک و فرد متخصص دیگر در این زمینه تهیه می شود. از این نمونه برای تست های آزمایشگاهی استفاده می کنیم. در مطلب زیر به صورت حرفه ای نحوه خونگیری را به صورت تصویری بحث خواهیم کرد.
-
آماده شدن برای خون گیری
گام اول از هر افدامی باید بیمار خود را دقیق شناسایی کنید تا به اشتباه از کسی دیگر خون نگیریم. در صورت وجود مشکل خاص در بیمار از فرد سوال کنیم یا در صورتی که پرونده آن را اختیار داریم اطلاعات را آن کسب کنیم. الزامات تهیه خون گیری را تا حد ممکن اجرا کنیم. برای نمونه اگر تستی نیازی به ناشتایی دارد باید مریض مدت زمان مشخصی را ناشتا باشد.

گام دوم که امروزه در کشور ما ایران اصلا رعایت نمی شود معرفی خود و تستی است که توسط ما انجام می شود. این حق بیمار است که اطلاعاتی در مورد تست و روش نمونه گیری بداند و ما وظیفه داریم هر سوالی در این زمینه که مربوط به نحوه نمونه گیری و همچنین روش خون گیری است را به بیمار توضیح دهیم. تجربه خودم ثابت کرده است که این روش برای کسب اعتماد مریض خیلی کمک کننده خواهد بود.

برچسبها: خونگیری خون گیری, نحوه خونگیری, تهیه نمونه خون, خون گرفتن
ادامه مطلب

کتاب عملی خونشناسی Dacie یکی از منابع پیشنهادی وزرات بهداشت برای رشته خونشناسی است. آخرین ویرایش این کتاب که در تاریخ 2011 به چاب رسیده است شامل مطالب به روز و بسیار کاربردی رشته خونشناسی علمی است. چاپ این کتاب از 61 سال پیش شروع شده است و الان به ویرایش یازدهم خود رسیده است. نسخه اولیه این کتاب توسط dacie تهیه شده بود ولی بعد این مدت الان توسط باربار جیمنز که از برجستگان رشته خونشناسی عملی است نگاشته می شود. کتاب در 26 بخش گرداوری شده است. این کتاب شامل:
- Collection and handling of blood
- Reference ranges and normal values
- Basic haematological techniques
- Preparation and staining methods for blood and bone marrow films
- Blood cell morphology in health and disease
- Supplementary techniques including blood parasite diagnosis
- Bone marrow biopsy
- Molecular and cytogenetic analysis
- Iron deficiency anaemia and iron overload
- Investigation of megaloblastic anaemia
- Laboratory methods used in the investigation of the haemolytic anaemias
- Investigation of the hereditary haemolytic anaemias
- Acquired haemolytic anaemias
- Investigation of abnormal haemoglobins and thalassaemia
- Erythrocyte and leucocyte cytochemistry
- Immunophenotyping
- Diagnostic radioisotopes in haematology
- Investigation of haemostasis
- Investigation of a thrombotic tendency
- Laboratory control of anticoagulant, thrombolytic and antiplatelet therapy
- Blood cell antigens and antibodies
- Laboratory aspects of blood transfusion
- Approach to the diagnosis and classification of blood diseases
- Laboratory organization and management
- Quality assurance
- Haematology in under-resourced laboratories
- دریافت کتاب (حجم 75 مگابایت) - اپلود اختصاصی
- برای دیدن لیست کل ایبوک های قرار داده شده در وبلاگ ، به اینجا بروید .
برچسبها: کتاب Dacie and Lewis Practical Haematology, کتای دیسی, کتاب عملی خونشناسی, کتاب Dacie 11
شمارش افتراقی گلبول های سفید یکی از چندین آزمایش شمارش کل سلول های خونی یا همان CBC هست. شکل و ریخت شناسی سلول های رده های مختلف خونی یکی از وظایف رشته علوم آژمایشگاهی است که با تجربه و اطلاعات تئوری به دست می آید. در گذشته مطالبی را در مورد ریخت شناسی انواع سلول های خونی در وبلاگ مغرفی کرده بودیم در ادامه، سلول های نوتروفیل را با هم مرور می کنیم. هما طور که می دونید نوتروفیل ها بیشترین درصد سلول های غیر اریتروئیدی را خون شامل می شوند و جز سیستم فاگوسیت چند هسته ای یا PMNs و اصلی ترین عضو این گروه است. میزان این سلول ها با تغییر تعداد و یا ظهور گرانول های مختلف در سیتوپلاسم نشان دهنده وجود عفونت یا بیماری ارثی است.
نوتروفیل باند(stab هم گفته می شود) یکی از اشکال رده های تولیدی نوتروفیل ها هست و قبل اینکه نوتروفیل به صورت بالغ در خون ظاهر شود باید از مرحله باند بگذرد. ریخت شناسی اتصالات هسته در این حالت از حالت متا نازک تر و از حالت بالغ کلفت تر است و هسته به صورت لوبوله دیده نمی شود.. نوتروفیل باند هم در مغز استخوان و هم در خون محیطی به مقدار مشخص(در افراد بالغ 3 تا 5 %) قابل روئیت است. افزایش بیش از حد آن را باندمی می گویند.


برچسبها: باند سل, سلول باند, باند نوتروفیل, band cell
از آنجا كه در تشخيص بيماريهاي خوني بررسي هاي آزمايشگاهي نقش مهم دارد و در درمان اين قبيل بيماريها نياز به انواع فرآورده هاي خوني سالم ميباشد، همچنين باتوجه به پيشرفتهاي وسيعي كه در زمينه خون شناسي صورت گرفته و به منظور تأمين نيروي انساني لازم در رشته خون شناسي آزمايشگاهي و بانك خون و انجام خدمات آزمايشگاهي بيماريهاي خوني، دوره كارشناسي ارشد خون شناسي آزمايشگاهي و بانك خون در دانشگاههاي واجد شرايط داير ميگردد.

برچسبها: ارشد هماتولوژی, خون شناسی, ارشد خون شناسی, ارشد خونشناسی
ادامه مطلب


